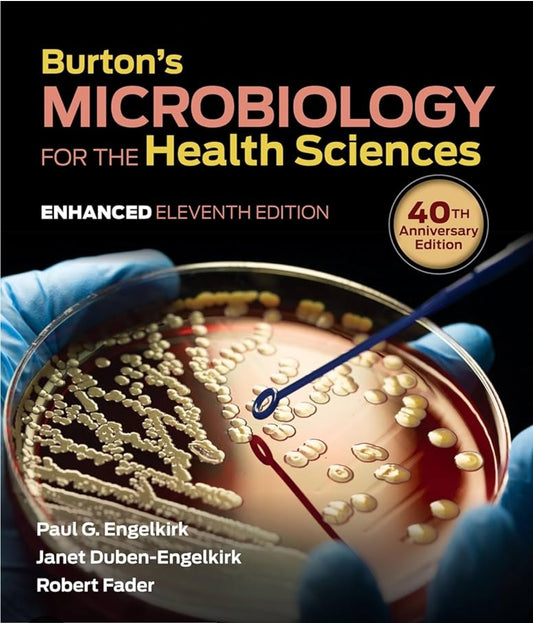

-
 Sold out
Sold outBuilding Code Compendium vol 1 and 2
Regular price $300.00 CADRegular priceUnit price per -
 Sold out
Sold outBuilding Code Compendium vol 1&2
Regular price $300.00 CADRegular priceUnit price per -
BUILDING CONSTRUCTION Principles,Materials and Systems THIRD EDITION
Regular price $200.00 CADRegular priceUnit price per -
 Sold out
Sold outBusiness a Changing world
Regular price $120.00 CADRegular priceUnit price per -
 Sold out
Sold outBUSINESS A Changing World
Regular price $83.00 CADRegular priceUnit price per -
Business a Changing World 8 th Canadian Edition
Regular price $70.00 CADRegular priceUnit price per -
Business Communication Polishing your Personal presence
Regular price $30.00 CADRegular priceUnit price per -
BUSINESS COMMUNICATION PROCESS & PRODUCT
Regular price $65.00 CADRegular priceUnit price per -
Business Driven Information Syatems
Regular price $80.00 CADRegular priceUnit price per -
Business driven Information Systems Eighth ed
Regular price $65.00 CADRegular priceUnit price per -
Business English Seventh Edition
Regular price $35.00 CADRegular priceUnit price per -
Business Essentials Looseleaf
Regular price $120.00 CADRegular priceUnit price per -
BUSINESS STATISTICS FOURTH CANADIAN EDITION
Regular price $180.00 CADRegular priceUnit price per -
BUSINESS STATISTICS FOURTH CANADIAN EDITION
Regular price $130.00 CADRegular priceUnit price per -
Business Strategy Development Application with McGraw Hill Connect
Regular price $130.00 CADRegular priceUnit price per -
Button's Microbiology for the Health Science - 11th Edition
Regular price $85.00 CADRegular priceUnit price per -
By the People Debating American Govern Fourth Edition
Regular price $60.00 CADRegular priceUnit price per -
Calculate with Confidence
Regular price $25.00 CADRegular priceUnit price per -
Calculate with Confidence
Regular price $60.00 CADRegular priceUnit price per -
Calculate with Confidence - 2nd Canadian edition
Regular price $70.00 CADRegular priceUnit price per -
Calculate with Confidence 2 nd edition
Regular price $70.00 CADRegular priceUnit price per -
Calculate With Confidence 2nd Canadian Edition
Regular price $80.00 CADRegular priceUnit price per -
Calculus 8th edition Single variable calculus Early Transcendentals
Regular price $50.00 CADRegular priceUnit price per -
Calculus Fear No More Second Edition
Regular price $35.00 CADRegular priceUnit price per -
Calculus Multivariable Third Edition
Regular price $80.00 CADRegular priceUnit price per -
Calculus Student Solution Manual 8th edition
Regular price $40.00 CADRegular priceUnit price per -
Campbell Essential Biology with student access code card
Regular price $130.00 CADRegular priceUnit price per -
 Sold out
Sold outCanadian Business English
Regular price $120.00 CADRegular priceUnit price per -
Canadian Business English
Regular price $150.00 CADRegular priceUnit price per -
 Sold out
Sold outCanadian Business English 8th ed
Regular price $130.00 CADRegular priceUnit price per -
Canadian Business English 8th Edition
Regular price $95.00 CADRegular priceUnit price per -
Canadian Business English 8th edition
Regular price $140.00 CADRegular priceUnit price per -
 Sold out
Sold outCanadian Business Law Fourth Edition
Regular price $85.00 CADRegular priceUnit price per -
 Sold out
Sold outCanadian Business Law Fourth Edition
Regular price $90.00 CADRegular priceUnit price per -
CANADIAN BUSINESS LAW TODAY SECOND EDITION
Regular price $130.00 CADRegular priceUnit price per -
Canadian Clinical Nursing Skills and Techniques
Regular price $120.00 CADRegular priceUnit price per